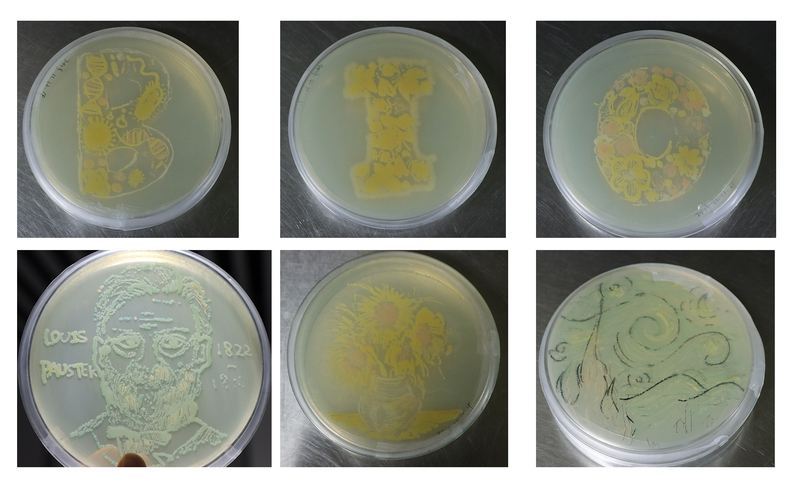

11月15日下午,生工学院师生在奉贤校区一食堂门口举行天目山野外实习成果展,展示生物科学2018级学生暑期赴浙江天目山野外考察的成果,与全校师生共同交流,探讨生命奥秘,激发同学们探索自然的热情,涵养敬畏生命的精神情怀。

天目山“大树华盖闻九州”的绝美画卷一展开,便吸引了大批师生怀着好奇心纷至沓来。生工学院党委副书记陆兵、副院长王启要,教务处副处长兼本科生招生办公室主任吴辉,以及生工学院党委副书记左鹏,应用生物学系主任吴海珍、副主任范立强,教学秘书高淑红、辛秀娟、周勉、范建华、叶江、李鹏飞、郑一涛以及学工委徐亚飞等老师皆来到活动现场参观和指导,与同学们共同分享此次野外考察的硕果。

平板画作,生命之诗。展台上最能体现生命科学世界独特之处,且最具吸引力的莫过于六个培养皿中的美丽图画了。与传统作品不同,此六幅画作皆由生长在固体培养基上的微生物构成。颜色丰富、形态各异的微生物和谐地组合在一起,构成惟妙惟肖、栩栩如生且具有生命力的作品——从宏观世界的花影重叠、彩蝶纷飞,到细胞、DNA的微观世界,生命的千姿百态构成了字母BIO(biology),向我们诉说着生物世界的奇妙无穷。
我校生物工程学院缘起抗生素制造工学专业,微生物是最重要的抗生素合成“工厂”,学子们用微生物绘制了伟大的微生物学家、微生物生理学开创者路易斯·巴斯德(Louis Pasteur),著名画家梵高的代表作《向日葵》和《星月夜》,以此致敬前辈和经典,也激励在生命科学领域积极探索勤奋求知的莘莘学子。
精美书签,礼赠师生。学子们以在天目山观察到的山水、花草、虫鱼、鸟兽为素材,结合所思所想,将自然的艺术融入精心设计的书签中。前来观摩的师生无不惊叹其精巧美丽、独具匠心,将一张张书签放入书卷,便留住了一片片湖光山色、鸟语花香。
细致解说,交流探讨。采自天目山的各种动植物标本以及土壤微生物的制片一起被带到活动现场,同学们争当解说员,分享了标本的制作、动植物的分类及特征、水体的取样与观察、鸟类的观察与鉴定等各方面的体验,交流场面热闹非凡。

生动体验,亲身参与。塑封机、显微镜、望远镜、取样器……野外考察的各种实验器材也都出现在展台上。同学们纷纷捡来喜欢的树叶,当场制作标本,或争先恐后地用显微镜观察微生物,或借望远镜抬头寻找天空的翅膀……电脑屏幕伴着宜人的音乐,讲述天目山的美好故事,重温天目山考察的美好记忆,引发了同学们对大自然的无限向往。
此次生物科学2018级联合团日活动不仅展示了野外实习的成果,而且增强了集体凝聚力,同时带领了更多同学走进奇妙的生物世界,激发他们亲近自然、探索真理、感悟生命的热情。






